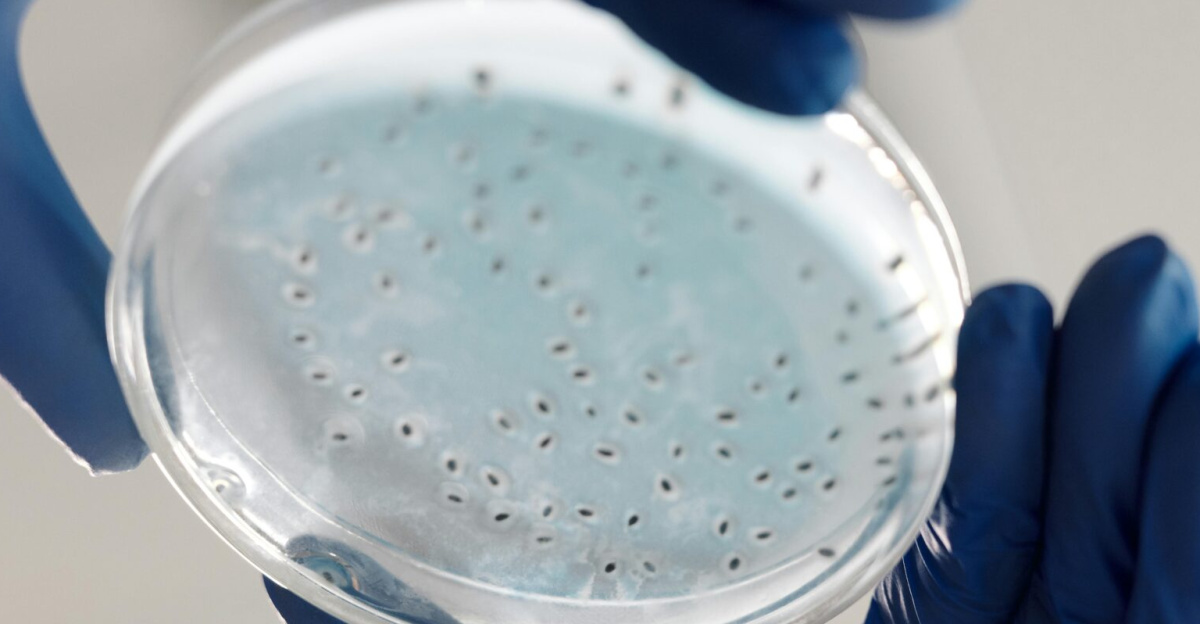
Close-up of hands in gloves holding a petri dish for microbiology analysis in a lab.

Deep in a hidden cave straddling the border of Albania and Greece, scientists have stumbled upon something extraordinary, a single spider web that spreads across 106 square meters, roughly the size of a small house. This tangled structure, discovered in November 2025, is the largest web ever recorded on Earth. According to ABC News, researchers describe it as a breathtaking example of how life adapts to survive in the toughest corners of our planet.
The web wasn’t just big, it was alive with tens of thousands of spiders cooperating in ways their species had never before. The sheer scale of the web, combined with its toxic underground environment, has triggered urgent scientific questions.
A Swarm Like No Other

When scientists took a closer look inside the dim, sulfur-laced cave, they counted a staggering 111,000 spiders living together under the same roof. For comparison, most spider colonies rarely reach even a few hundred individuals. The dense, shimmering web that filled the cave’s walls, ceilings, and crevices was both terrifying and mesmerizing.
Researchers think the colony’s unusual size could be a survival move, an evolutionary response to the cave’s harsh conditions. The air there is toxic with hydrogen sulfide, yet food is plentiful, a combination that forces cooperation over competition. In such a tight environment, spiders appear to have traded their solitary habits for teamwork, forming what scientists call a mega-colony.
When Loners Become a Crowd

To understand the shock of this discovery, it helps to know that the spiders involved, Tegenaria domestica (common house spider) and Prinerigone vagans (sheet weaver), are famous for being loners. In normal settings, these spiders avoid each other and sometimes even fight when they meet. But here, the rules have changed. Unlike social insects such as ants or bees, spiders are typically solitary hunters.
Yet, inside this suffocating cave, their instincts shifted dramatically. Walls glimmer with silk, layers upon layers spun not by one, but thousands working as a silent, coordinated force. No previous studies have shown such large-scale cooperation among these particular species. The discovery challenges long-standing ideas about what drives social behavior in the animal kingdom.
Survival Under Pressure

Life in this cave is a constant test. The air holds high levels of hydrogen sulfide, a gas so toxic it can kill most animals within minutes. Yet, somehow, this community of spiders thrives. Scientists believe the secret lies in two key factors: stress and opportunity. The cave’s thick, sulfur-drenched air is balanced by an abundance of small insects, a steady food source that rewards cooperation over conflict. According to Subterranean Biology, this mix of danger and plenty likely forced the spiders to change their strategies.
Instead of competing for limited resources, they began collaborating. Researchers compare it to human societies uniting during crises, when survival depends on pooling strength. Over time, these survival pressures may have triggered genetic and behavioral changes, revealing how evolution can accelerate when life is pushed to its limits. This network of silk and survival now offers scientists a real-time look at evolution’s adaptability in action.
Shattering World Records

On November 10, 2025, the research team led by Dr. Zoltán Urák officially unveiled what they confirmed as the world’s largest spider web. Spanning an entire cave system shared by Albania and Greece, the web is home to 111,000 spiders working in remarkable unison. Genetic studies conducted on collected samples reveal something even more incredible, these spiders show signs of localized adaptation, possibly making them genetically distinct from their surface-dwelling relatives.
This find is not only a world record but also a breakthrough in understanding cooperative evolution among non-social spiders. The researchers now hope to use DNA sequencing to trace how quickly such cooperation emerged.
A Cross-Border Wonder

The cave holding the record-breaking spider web lies right on the line between Albania and Greece, a region rich in both culture and ecological mystery. This rare location has sparked collaboration across borders, with scientists from both countries joining forces to study the phenomenon. Conservation officials are considering new rules to limit human access to the area, fearing that vibration, light, or pollution could easily damage the fragile habitat.
The growing partnership marks a rare moment where science, policy, and nature intersect for a common cause. Beyond the excitement of breaking records, this newfound cooperation between two neighbors could become a blueprint for managing shared ecosystems responsibly, especially those hidden beneath the Earth’s surface.
Locals Speak Out

The discovery has stirred as much fascination as fear among locals. People in nearby villages have visited the area for generations, but no one ever imagined that a massive spider colony was lurking in the darkness below. Scientists, however, have urged communities to stay cautious. The web and its residents are extremely sensitive to light, noise, and even temperature changes.
Disrupting the delicate balance of the cave could cause irreversible harm. Local tourism boards are weighing how to balance curiosity with conservation. The story has spread far beyond Albania and Greece, drawing nature enthusiasts from around the world.
When Rivals Become Teammates

This discovery shocked experts for another reason: two competing spider species, Tegenaria domestica and Prinerigone vagans, are cohabiting peacefully. The numbers alone are astonishing, over 69,000 house spiders and around 42,000 sheet weavers live side by side. Normally, these species compete fiercely for food and space. Yet here, they’re cooperating with surprising harmony.
The interspecies teamwork might be rooted in shared necessity, abundant insect prey reduces competition, while the cave’s danger pushes unity over rivalry. It’s a living example of how cooperation can emerge from crisis, echoing themes seen in forming human alliances during disasters.
Patterns in Progress

Scientists see this discovery as part of a much bigger picture in the story of evolution. Around the world, certain species have shown rapid adaptation when placed in hostile, isolated, or resource-rich settings. Examples include blind fish that evolved special navigation senses in caves, and insects developing new diets in polluted environments.
The Albania-Greece cave is now a living model of evolutionary acceleration. The megacolony shows how pressure can spark cooperation, challenging old assumptions about competition as the main driver of evolution.
Built on Microbial Power
Every big ecosystem starts small, and in this cave, it begins with microscopic life. Beneath the slick stone walls, sulfur-loving microbes produce energy from chemical reactions rather than sunlight, forming the base of a unique food web. These microbes sustain clouds of tiny flies called chironomids, estimated at over 2.4 million individuals.
Those flies, in turn, feed the vast spider colony. This entire system operates like an underground factory powered not by photosynthesis, but by chemistry. The process mirrors those found in deep-sea vents, hinting that extreme environments on Earth may mirror conditions that once existed on other planets.
The Tensions Beneath the Web

Even in such a vast and seemingly peaceful spider metropolis, harmony isn’t absolute. Biologists have noticed small, but telling, skirmishes within the colony. Some spiders guard prime hunting spots fiercely or chase off neighbors who get too close. The battles are rarely fatal, suggesting an evolving balance between competition and cooperation.
These tensions could be clues to how social systems stabilize in nature when individuals must compromise survival with collaboration. By watching these interactions over time, scientists hope to understand which behaviors persist and which evolve.
The Team Behind the Breakthrough

The global spotlight now shines on the multidisciplinary team that made this discovery happen. Leading the project is Dr. Zoltán Urák, a Romanian zoologist known for exploring Europe’s underground ecosystems. He worked alongside the Albanian Institute of Biology and Greek cave ecologists, creating one of the most successful cross-border science collaborations in recent years.
Without this cooperation, experts say, the discovery would likely have remained hidden. The project’s collaboration model is now being discussed at European environmental forums as an example of how joint research efforts can overcome both natural and political barriers.
Racing to Protect a Fragile World

As news of the spider colony spread, conservation groups began calling for immediate action to protect the cave and its delicate biodiversity. The web’s structure, the colony’s balance, and the cave’s chemistry form a fragile system that could collapse with the slightest human interference. Proposed protective measures include restricted entry, continuous environmental monitoring, and limits on tourist access.
The Albanian Ministry of Environment is already reviewing the area for special ecological status. The conservation push reflects a growing awareness that recording nature’s marvels isn’t enough, they must be shielded from human curiosity and environmental risk if current generations are to preserve them.
A Healthy Dose of Skepticism

While most scientists are amazed, not everyone accepts this discovery without question. A few experts are urging caution before declaring it a one-of-a-kind event. Her view is not doubt but curiosity, an invitation for further exploration.
Other researchers agree, noting that limited access to underground environments means surprises still await discovery. The skepticism is healthy, ensuring the findings remain grounded in scientific rigor.
What Comes Next

The balance that made the web possible, abundant flies, sulfur-rich chemistry, and steady humidity, might not last forever. Researchers wonder if a small shift in cave temperature or water flow could undo the entire ecosystem. Teams plan to return annually to measure population numbers, air quality, and microbial activity.
Whether this megacolony endures or collapses could reveal valuable lessons about resilience and adaptation under stress. For scientists watching closely, the cave is not just a natural wonder, it’s a living experiment unfolding beneath their feet.
Policy Decisions Ahead

The unbelievable discovery of the spider megacity is already influencing environmental policy talks in both Albania and Greece. For the first time, officials from both nations are working together on a joint management plan designed to protect the cave and its inhabitants from overexposure. Scientists are providing data to help policymakers draft guidelines for research visits, habitat protection, and local community education.
The challenge lies in balancing scientific curiosity with ecological safety. Both governments are optimistic that these efforts could serve as a model for future collaborations in biodiversity protection.
Global Ripples

Word of the discovery has spread worldwide, catching the attention of international scientific bodies like the International Union for Conservation of Nature (IUCN). The cave has now been proposed as a potential Living Laboratory for studying adaptation in extreme environments.
Representatives from major research universities are already expressing interest in conducting controlled studies there. The international spotlight might bring resources, partnerships, and stricter conservation safeguards.
Danger in the Air

While the cave thrives with life, it’s also incredibly dangerous for humans. Tests reveal that hydrogen sulfide levels can reach 14 parts per million in the air and 65 milligrams per liter in the water, enough to pose serious health risks.
That means every expedition must follow strict safety procedures like protective masks, ventilation systems, and real-time gas monitoring. Reports noted that researchers limit each cave visit to less than two hours to prevent prolonged exposure to hazardous conditions.
Despite these precautions, scientists are driven by the chance to understand how life survives in such a toxic place. The conditions mirror some of Earth’s earliest ecosystems, offering clues to how simple organisms paved the way for complex life.
Changing Hearts and Minds

Before the discovery, spiders were often seen as pests or symbols of fear in the local communities. That view is changing fast. Thanks to new educational programs and public talks, many residents now see these creatures as ambassadors of adaptation and endurance. Schools in Albania and Greece have even started using the megacolony as a lesson in biology and environmental science.
Art projects, nature clubs, and local tourism initiatives have followed, all inspired by the story of resilience deep below their feet. Scientists believe such cultural shifts are vital for long-term conservation.
A Message from the Web

The giant spider web beneath the Albania-Greece border has become more than just a natural wonder, it’s a symbol of life’s persistence. In a world facing an environmental crisis, this discovery shows that adaptation can create cooperation in the most unlikely of species.
The megacolony forces scientists and citizens alike to rethink how nature responds under pressure. As research continues, protecting this delicate environment will remain a global responsibility.